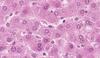

Histo - GI 3 Flashcards
What are the 5 characteristics of the liver?
- Largest gland in the human body
- 4 lobes
- Capsule
- thickens at porta hepatis (hilum)
- Blood supplied by portal v & hepatic a
- enter at hilum
- Bile, blood, lymph
- exit at hilum
How does liver receive blood supply?
-
Dual blood supply
- hepatic a
- oxygenated blood
- hepatic portal v
- deoxygenated blood
- hepatic a
-
Blood to hepatocytes = mixture of both blood types
- hepatic sinusoids have both
- drains to central v
What is this?

Liver (pig)
Metabolic Functions:
- synthesis of cholesterol & bile salts
- gluconeogenesis
- deamination of AA
- storage of iron, glucose, lipis, vit A
- breakdown of glycogen
- detox
- RBC removal
Exocrine Fxn:
- Bile secretion
Endocrine Fxn:
- Albumin
- Fibrinogen
- Coagulation factors
What is this?

Liver (Human)
- Hepatocytes
- polygonal cells w/ large, central nuclei (or 2)
- Hepatic lobules
- cords of liver cells (linear arrangement)
- w/ bile canaliculi & sinusoid in btw
- central v.
- reticular fibers & CT
- cords of liver cells (linear arrangement)
- Portal Triad in space of Kiernan
- (1) portal v (2) hepatic a (3) bile duct
- Sinusoids
-
Space of Disse
- btw endothelial cells & hepatocytes
- aka: perisinusoidal space
- drains 2 types of blood toward central v.
-
Space of Disse
Explain the Organization of the Liver
What is this?
Liver Structure
Blood flow in liver:
- Branches of portal v & hepatic a in Portal Triad –>
- Sinusoids –>
- mixing of oxygenated & deoxygenated blood
- Central v. –>
- Leaves liver via hepatic v.
Note:
- Blood flow is opposite bile flow
What is this?

Portal v & Hepatic a
What is this?

Space of Moll
- btw last hepatocyte & start of CT of space of kiernan
- start of lymph drainage
Note:
- lymph drains towards hilum
What is this?
Liver Microvasculature
What is this?
Liver Sinusoids
What is this?
Liver Sinusoid
What is this?
Sinusoids in the liver
What is this?

SEM of Liver Sinusoids
- You can see the large holes in the sinusoid
How does the Bile Flow in the Liver?
Bile Flow in the Liver
- Hepatocytes –>
- Bile canaliculis –>
- has tight jxns
- Canal of Hering or cholangiole
- has small, low epithelium layer (but still w/in the lobule of hepatocyte, before duct)
- Bile ductule in portal triad –>
- Bile ducts –>
- Leave liver thru R & L hepatic ducts –>
- merge w/ common hepatic duct
- Connects to cystic duct –> gallbladder OR
- Connect to common bile duct –> duodenum
Notes:
- Opposite of blood flow
What is this?
Bile Canaliculis
What is this?

Canal of Hering aka Cholangiole
- bile canaliculi are too small to see at LM
What is this?

Bile Ductule in Portal Triad
What is the relationship btw Blood & Bile flow in the Liver?
Flow in the Liver
- Blood
- from hepatic a & portal v in portal triad –>
- towards central v
- leaves liver via hepatic v
- Bile
- Hepatocytes –>
- Bile canaliculus –>
- canal of Hering (AKA cholangiole) –>
- bile ductule in portal triad –>
- bile duct
What are the 4 structures in this image?

- Portal v
- Hepatic a
- Bile duct
- Space of Kiernan
What is the structure of hepatocytes?
Hepatocyte Structure
- Lots of RER & SER
- Mitochondria w/ both:
- shelflike & tubular cristae
- Lipid droplets
- Microvilli
- Bile canaliculus sealed by tight jxns
- Space of Disse
- space between microvilli & endothelium
- Lots of peroxisomes
What are the Membrane Domains of Hepatocytes?
Btw 2 hepatocytes
- bile canaliculus
- apical domain
- tight jxns seal canaliculus
Btw hepatocyte & endothelial cells of sinusoid
- in basolateral domain
- Space of Disse
- microvilli from hepatocyte
- collagen
- Ito cells (vit A storage)
- Pit cells (NK cells)
- Processes of Kupffer cells
What is this?

Space of Disse (aka Perisinusoidal Space)
- Found in Space of Disse
- Microvilli from hepatocyte
- Collagen
- Ito cells or hepatic stellate cells
- vit A storage
- become myofibroblasts w/ liver injury
- Kupffer cells
What are the 3 Concepts of Liver Organization?
Classic lobule (Hexagon)
- Central vein as the center & portal triads at corners
- Emphasizes flow of blood (endocrine fxn)
- portal triads –> central vein
Portal lobule (Triange
- Bile duct as the center & 3 central veins
- Emphasizes flow of bile (exocrine fxn)
- hepatoctypes –> bile duct
Hepatic acinus (Diamond)
- Diamond shape w/ 2 central veins & 2 portal triads
- Emphasizes metabolic fxn
- oxygenated blood –> hepatocytes
- Zone 1 = most O2 (most toxins!)
- Zone 3 = least O2 (most damage!)
What is this?

Hepatic Acinus
Basics:
- Central axis follows a branch of hepatic a
- in portal space of Kiernan
- 3 concentric arcs = zones
Zones:
- 1 = closest to hepatic a
- most O2
- 2 = intermediate
- 3 = clostest to central v
- least O2 & least nutrients
- most glycolysis, lipid formation, drug biotransformation happens
- 1st area to…
- have fatty accumulation
- undergo ischemic necrosis (least able to fight toxins)
What is involved with Liver Regeneration?
Basics:
- Hepatocytes grow slowly
- Hepatocyte death causes mitosis
Surgery:
- Sx removal of part of liver causes mitosis of remaining hepatocytes
- Living donor
- Compenstory hyperplasia
Liver Stem cell:
- Oval cells
- present btw cholangiocytes (canal of Hering/canaliculus)
What is this?
Gall Bladder
Basics:
- Stores & concentrates bile
- Attached to lower surface of liver
- has BOTH serosa & adventitia
- Mucosa & Muscularis externa (thin)
- Mucosal folds
Structure:
- Simple columnar epithelium
- LP underneath mucosa
- NO muscularis mucosa!
- Intercellullar space on BL surface
- due to bile concentration
Diagnostic feature:
- Rokitansky-Aschoff sinuses (crypts) - RA crypts
- Mucosal folds = artifactes
What is this?

Gall Bladder
What is this?

Gall Bladder Epithelium and Lamina Propria
What are the 3 Steps for the Release of Stored Bile?
- Fats in the small intestine stimulate release of cholescytokinin from APUD cells
- Cholecystokinin causes contraction of the gallbladder muscularis
- Bile goes into the duodenum
What is this?

Pancreas
Exocrine (and Endocrine)
Basics:
- Has BOTH exocrine (digestive enzymes) & endocrine (hormones)
- Retroperitoneal
Structure:
- CT capsule
- CT septa forms lobules
- Reticular fibers
- Pancreatic islets & serous secreting acini w/ duct system
- Acini = have BL w/ reticular fibers beneath + capillaries
Exocrine vs. Endocrine
Exocrine:
-
Serous secreting acini
- cells have apical granules
- Duct system
- Secrete zymogens
- 4 mechanisms for preventing self-digestion
- enzymes in vesicles
- inactivated by pH in vesicle
- stored as proenzymes
- inhibitory molecules keep enzymes inactive
Endocrine:
- Cells secrete into the vascular system
- Islets of Langerhans
- Usually lighter staining than exocrine pancrea
- Not easy to distinguish cell types
What is this?

Pancreas Structure
- Intralobular ducts (D)
- lined by simple columnar epithelium
- Serous acini (A)
- Ducts & blood vessels in CT (V)
What is this?

TEM of Pancreatic Acinar Cell
- Secretory granules
- Zymogens
- Released by exocytosis induced by CCK
What is this?

Intercalated and Intralobular Ducts in Exocrine Pancreas
-
Intercalated duct (starts within the acinus and is seen
as a centroacinar cell)- simple squamous or low cuboidal
- Secrete bicarbonate ions under influence of secretin
-
Intralobular duct
- simple cuboidal to simple columnar epithelium
- w/in a lobule & surrounded by CT
-
Interlobular duct
- simple columnar or stratified columnar outside of lobules
-
Zymogens
- leave panncreas via main & accessory pancreatic ducts
- go to the duodenum
Comparison of Serous Glands
Parotid Salivary Gland
- No centroacinar cells
- Striated ducts
- No islet of Langerhans
- Myoepithelial cells
Pancreas
- Centroancinar cells
- No striated ducts
- Islets of Langerhans
- No myoepothelial cells
What is this?

Centroacinar cell
Comparison of Duct Systems
-
Salivary Glands
- Intercalated –> Striated –> Excretory (Interlobular)
- intercalated does NOT begin w/in acinus
- Intercalated –> Striated –> Excretory (Interlobular)
-
Pancreas (exocrine)
- Intercalated –> Intralobular –> Interlobular
- Intercalated begins w/ acinus
- visulize as centroacinar cells
What is this?

Interlobular Duct in Exocrine Pancreas